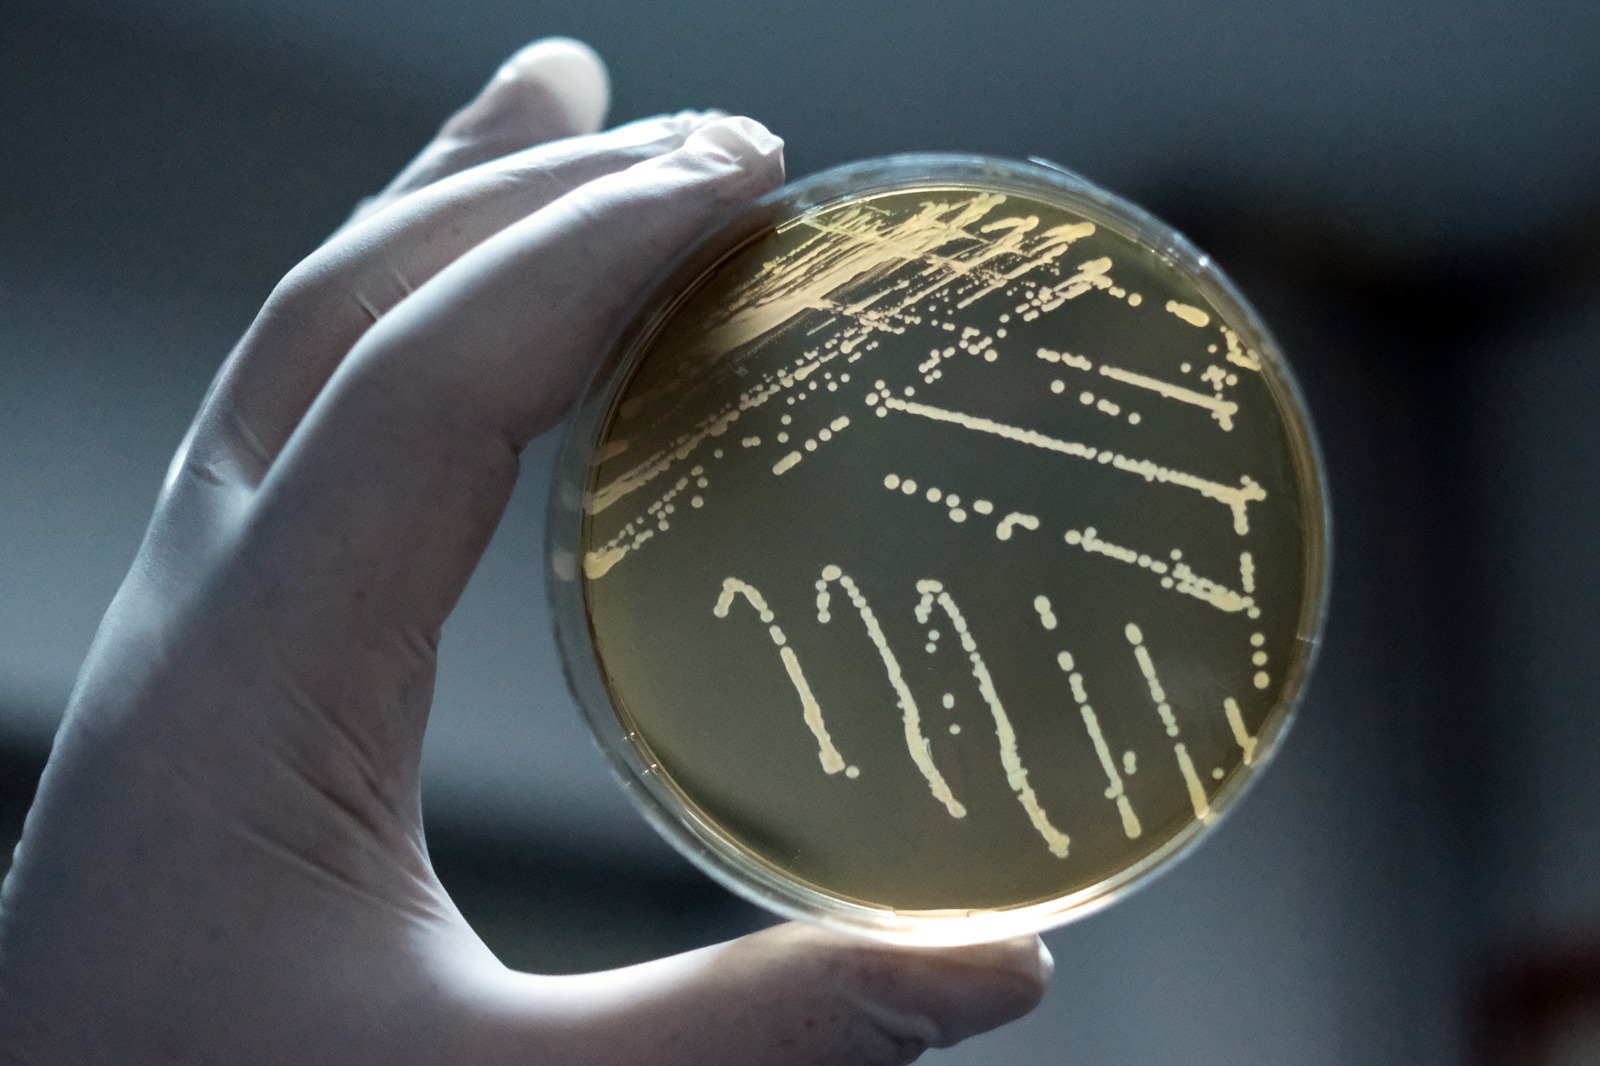

Gıda sanayinde fermente ürünlerde starter kültür olarak maya, küf ve bakterilerin değişik formülasyonları kullanılmaktadır. Başta süt sanayi olmak üzere ülkemizde gıda sanayinin ihtiyaç duyduğu starter kültürlerin büyük çoğunluğu yurt dışından temin edilmektedir. Mevcut mikroorganizma gen kaynaklarımızın tespit edilmesi, muhafazası, sürdürülebilirliğini sağlamak amacıyla Ensitü bünyesinde uluslararası normlarda Gıda Starter Kültür Gen Bankası kurulması amacıyla proje hazırlanmıştır. Proje, 2013 yılında Kalkınma Bakanlığına (İmalat-Gıda sektörü) sunulmuş ve kabul edilmiştir. Ocak 2014'te başlayan projenin başlangıç toplam bütçesi 15.8 milyon TL'dir. 2014 yılında başlayan proje ile gerekli olan altyapı kurulmuştur. 2017 yılında resmi olarak açılmıştır. 2020 yılından itibaren Enstitü bünyesinde bölüm başkanlığı şeklinde faaliyetlerine devam etmektedir. 2021 yılında Tarımsal Araştırmalar ve Politikalar Genel Müdürlüğü tarafından tesis ismi Süt Ürünleri Gen Bankası olarak değiştirilmiştir.

Proje kapsamında kurulan altyapı Mikrobiyoloji Laboratuvarı, Moleküler Biyoloji Laboratuvarı, Genetik materyal muhafaza birimleri ve süt ürünleri pilot tesisinden oluşmaktadır.
Geleneksel gıdalarımıza ait genetik yapının korunması ve sürekliliğinin sağlanması, kültür koleksiyonu kapsamında ülkemizin değişik yörelerinden elde edilen fermente ürünlerdeki mikroorganizmaların tespiti ve tanımlanması, özel sektörün ihtiyaç duyduğu endüstriyel kültürlerin ticari olarak üretimine destek sağlanması ve ticari öneme sahip yeni türlerin belirlenebilmesi amacıyla kurulmuştur.
Öncelikli olarak süt ve süt ürünleri için çalışmalar başlanmış bu amaçla süt ürünleri pilot tesisi kurulmuştur.
Laktik asit bakterilerin tanımlanması amacıyla enstitü uluslararası geçerliliği olan 3 yöntem kullanılmaktadır.
Bunlar MALDI- TOF MS, Riboprinter, NGS (Yeni nesil sekans analizi)'dir.
MALDI- TOF MS :
Mikroorganizmaların protein yapılarını iyonize ettikten sonra elektrik alandan geçirerek protein profillerinin çıkarılması esasına dayanır. Elde edilen profiller sistemin kütüphanesindeki verilerle karşılaştırılarak tanımlama yapılır. Tanımlama için temel alınan mikroorganizma proteinleri ise esasen çevresel koşullardan az etkilenen ribozomal proteinlerden oluşmaktadır. Hızlı tanımlama için en etkin yöntemlerdendir.
Riboprinter Cihazı:
Riboprinter ile mikroorganizmalara iat 5S, 16S ve 23S gen bölgeleri baz alınarak mevcut kütüphanesi ile kıyaslanması yoluyla tanımlama yapılmaktadır.
NGS (Yeni nesil sekans analizi):
Yeni nesil dizileme (next-generation sequencing, NGS) genetik teknolojisi, tek bir örnekten alınan milyonlarca parçaya ayrılmış bir DNA molekülünün her bir parçasının aynı anda ve uyum içerisinde paralel olarak işlenmesini temel alır. Elde edilen dizileme sonucu uluslararası kütüphanelerle karşılaştırılarak mikroorganizma tanımlanması gerçekleştirilir.